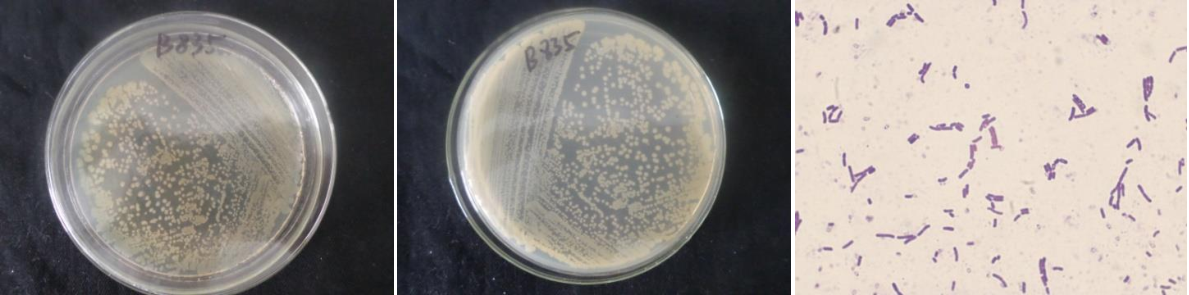

Loading...
| StrainNO | B835 |
| Classification | Bacillus |
| 16s rDNA sequence | GATTAGAAGCTTGCTTCTATGACGTTAGCGGCGGACGGGTGAGTAACACGTGGGCAACCTGCCTGTAAGACTGGGATAACTTCG GGAAACCGAAGCTAATACCGGATAGGATCTTCTCCTTCATGGGAGATGATTGAAAGATGGTTTCGGCTATCACTTACAGATGGG CCCGCGGTGCATTAGCTAGTTGGTGAGGTAACGGCTCACCAAGGCAACGATGCATAGCCGACCTGAGAGGGTGATCGGCCACAC TGGGACTGAGACACGGCCCAGACTCCTACGGGAGGCAGCAGTAGGGAATCTTCCGCAATGGACGAAAGTCTGACGGAGCAACGC CGCGTGAGTGATGAAGGCTTTCGGGTCGTAAAACTCTGTTGTTAGGGAAGAACAAGTACAAGAGTAACTGCTTGTACCTTGACG GTACCTAACCAGAAAGCCACGGCTAACTACGTGCCAGCAGCCGCGGTAATACGTAGGTGGCAAGCGTTATCCGGAATTATTGGG CGTAAAGCGCGCGCAGGCGGTTTCTTAAGTCTGATGTGAAAGCCCACGGCTCAACCGTGGAGGGTCATTGGAAACTGGGGAACT TGAGTGCAGAAGAGAAAAGCGGAATTCCACGTGTAGCGGTGAAATGCGTAGAGATGTGGAGGAACACCAGTGGCGAAGGCGGCT TTTTGGTCTGTAACTGACGCTGAGGCGCGAAAGCGTGGGGAGCAAACAGGATTAGATACCCTGGTAGTCCACGCCGTAAACGAT GAGTGCTAAGTGTTAGAGGGTTTCCGCCCTTTAGTGCTGCAGCTAACGCATTAAGCACTCCGCCTGGGGAGTACGGTCGCAAGA CTGAAACTCAAAGGAATTGACGGGGGCCCGCACAAGCGGTGGAGCATGTGGTTTAATTCGAAGCAACGCGAAGAACCTTACCAG GTCTTGACATCCTCTGACAACTCTAGAGATAGAGCGTTCCCCTTCGGGGGACAGAGTGACAGGTGGTGCATGGTTGTCGTCAGC TCGTGTCGTGAGATGTTGGGTTAAGTCCCGCAACGAGCGCAACCCTTGATCTTAGTTGCCAGCATTTAGTTGGGCACTCTAAGG TGACTGCCGGTGACAAACCGGAGGAAGGTGGGGATGACGTCAAATCATCATGCCCCTTATGACCTGGGCTACACACGTGCTACA ATGGATGGTACAAAGGGCTGCAAGACCGCGAGGTCAAGCCAATCCCATAAAACCATTCTCAGTTCGGATTGTAGGCTGCAACTC GCCTACATGAAGCTGGAATCGCTAGTAATCGCGGATCAGCATGCCGCGGTGAATACGTTCCCGGGCCTTGTACACACCGCCCGT CACACCACGAGAGTTTGTAACACCCGAAGTCGGTGGAG |
| Strain Morphology Photos | |
| Morphological Description | Colony round;clam white;edge serrated;Edge slightly convex;concentric ring;center convex;Many wrinkles;slippy;sticky;mucoid;strain:Rod;having spore;Spores are intermediate |